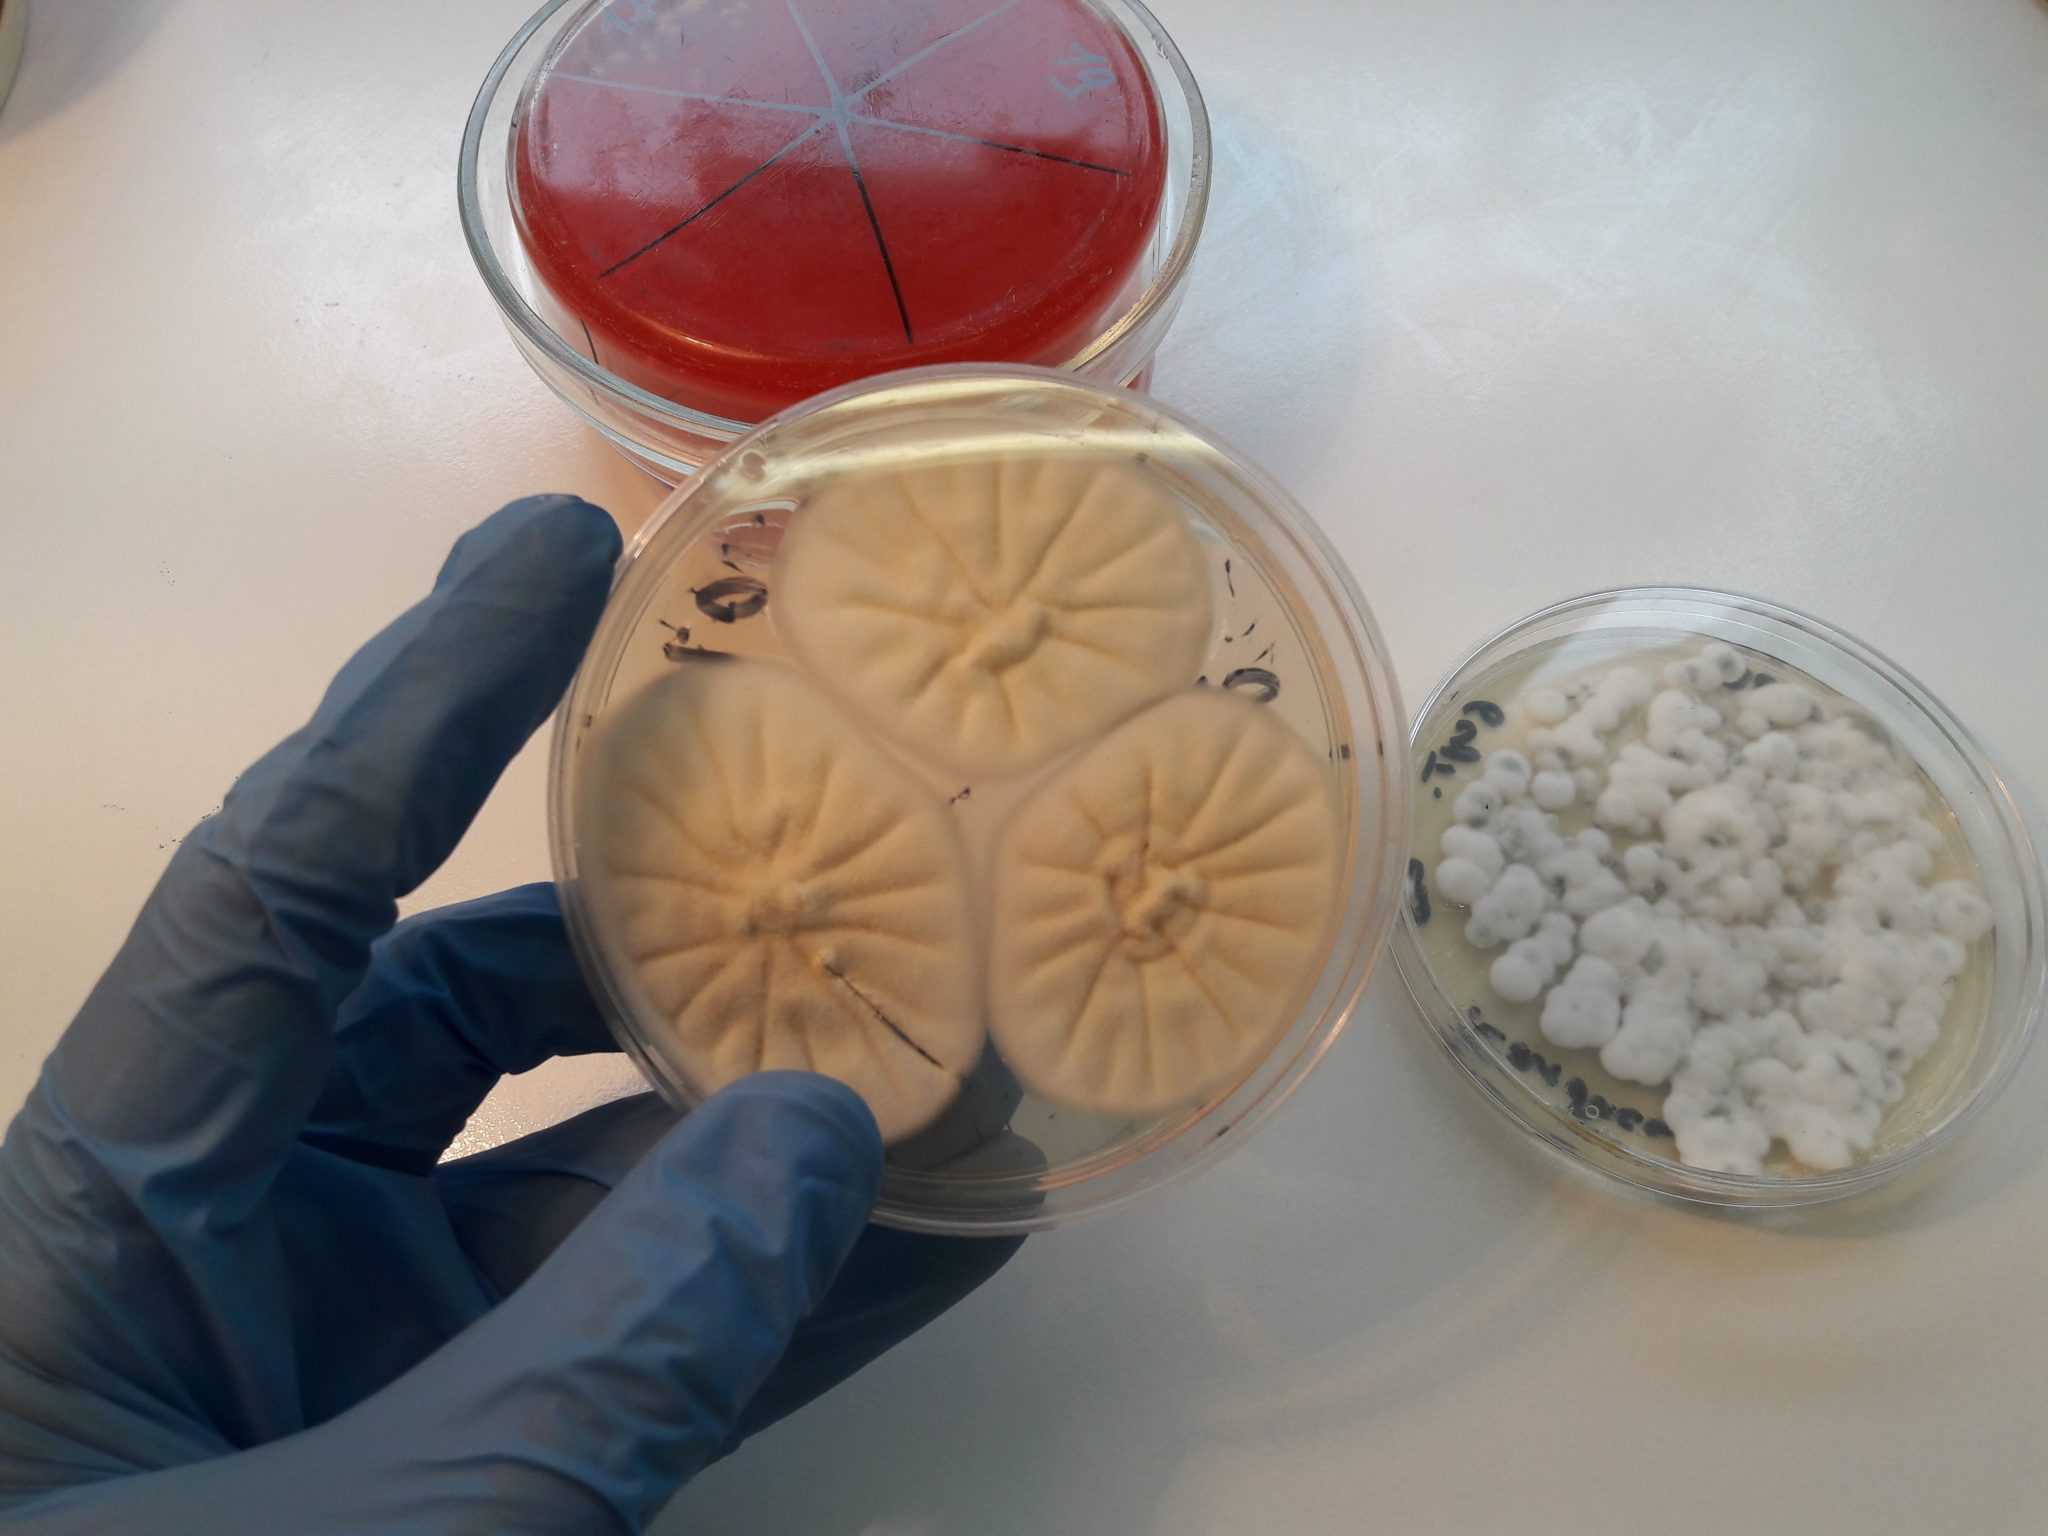

Анализ на кандидоз – лучший способ уточнить, действительно ли Вы страдаете этим заболеванием. На самом деле, есть много способов узнать это, но сначала все же лучше обратиться к врачу.
В ходе консультации врач задаст Вам несколько вопросов: какие симптомы Вы ощущаете, как давно они появились, какие препараты Вы сейчас принимаете. Вам нужно быть честным в ответах, особенно если это уже не первый случай инфекции. Хорошо, если инфекция возникла впервые, но если у Вас уже есть подобный анамнез, то есть хороший шанс избежать дальнейших рецидивов.
Самым эффективным методом анализа является взятие мазка и обследование его в лаборатории. Если у Вас обнаруживается превышающее норму количество дрожжей, то это кандидоз. Врач также может взять анализ крови, потому что кандидоз может быть вызван диабетом или какой-либо другой проблемой со здоровьем.
Некоторые врачи также проводят гинекологический осмотр, потому что воспаление кожи наружных половых органов может распространиться на влагалище и шейку матки. При осмотре врач может обнаружить повышенную сухость или белые пятна на стенках влагалища.
Если анализы подтвердили наличие кандидоза, врач должен выбрать тактику лечения.
Что же происходит дальше? Если болезнь случилась впервые, врач может назначить семидневный курс лечения, который избавит Вас от симптомов. Даже если это повторный случай инфекции, Вы можете попробовать таблетки, кремы или суппозитории, в зависимости от рекомендаций врача.
Исследования показывают, что наличие кандидоза повышает восприимчивость к заражению ВИЧ-инфекцией, так как раздражение влагалища облегчает проникновение этого опасного вируса в кровь. Хотя это случается нечасто, женщины с дрожжевой инфекцией, устойчивой к лечению, должны пройти обследование на другие причины, потому что врач уже исключил чрезмерное использование антибиотиков, которые иногда могут служить причиной этого заболевания.
Некоторые люди используют домашние средства для лечения кандидоза. Примеры таких средств: клюквенный сок, уксус, йогурт, простокваша, оливковый лист, экстракт грейпфрута, сорбат калия, ацидофилин и многие другие, более подробно о которых Вы можете узнать из «Полного руководства по всестороннему восстановлению здоровья».
В течение всего периода лечения воздерживайтесь от сексуальных контактов, потому что Вы можете заразить партнёра. Более того, Вы можете передать инфекцию, даже если Ваш партнёр пользуется презервативом, потому что кремы на масляной основе, применяемые для лечения, могут разрушать латекс.
Анализ на кандидоз – лучший способ для врача подтвердить или опровергнуть Вашу дрожжевую инфекцию, даже при наличии симптомов. Можно было бы подумать, что в этом нет необходимости и что это пустая трата времени и денег, но врач всегда должен выполнять определённые необходимые процедуры, чтобы назначить правильное лечение конкретно Вашего состояния.